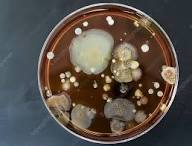

Prehľad niektorých vedeckých štúdii
24.01.2026
Niektoré vedecké štúdie a publikácie,
ktoré sa zaoberajú probiotickými čistiacimi systémami, vysvetľujú ich účinky a porovnávajú ich s tradičnými chemickými metódami. Nižšie uvádzam relevantné peer-reviewed štúdie a články, ktoré môžeš použiť ako vedecký základ (dôkazy) pre tvrdenia v texte:
1) Disinfectant, Soap or Probiotic Cleaning? Surface Microbiome Diversity and Biofilm Competitive Exclusion
Dezinfekcia, mydlo alebo probiotické čistenie? Diverzita povrchového mikrobiomu a konkurenčná exklúzia biofilmov
- Porovnáva vplyv chemickej dezinfekcie, normálneho mydla a probiotického čističa (obsahujúceho Bacillus spóry) na mikrobiom povrchov v prostredí nemocnice.
- Zhromažďuje dáta o konkurenčnej exklúzii patogénov a vlivu rôznych režimov čistenia na mikrobiálnu komunitu.
Dôležité body z tejto štúdie:
- Povrchy ošetrené probiotickým čističom a bežným mydlom mali mikrobiom, ktorý lepšie súťaží s patogénmi ako povrchy ošetrené dezinfekciou.
- Toto je jedna z mála štúdií, ktorá priamo testuje probiotické čistenie na reálnych povrchoch po dlhšom období. potláčať patogényprodukcia bacteriocínov
2) Bacillus-based probiotic cleansers reduce the formation of dry biofilms on common hospital surfaces
Probiotické čističe na báze baktérií Bacillus znižujú tvorbu suchých biofilmov na bežných nemocničných povrchoch
- Tzv. probiotické čističe založené na Bacillus spp. dokázali znížiť tvorbu suchých biofilmov (ktoré predstavujú riziko HAIs) na rôznych povrchoch v nemocničnom prostredí.
Kľúčové zistenia:
- Aplikácia probiotického prípravku viedla k >97,7 % zníženiu suchých biofilmov E. coli a S. aureus.
- Bacillus baktérie sa mohli na povrchu premeniť zo spór na aktívne bunky a kolonizovať povrch.
3) Impact of a Probiotic-Based Cleaning Intervention on the Microbiota Ecosystem of Hospital Surfaces: Focus on the Resistome Remodulation
Vplyv probiotického čistenia na mikrobiálny ekosystém nemocničných povrchov so zameraním na prestavbu rezistomu
- Štúdia hodnotí vplyv probiotického čistenia na rezistentné gény (resistome) a celkový mikrobiálny profil povrchov v nemocnici.
Zistené efekty:
- Probiotické ošetrenie znížilo výskyt génov rezistencie bez selekcie rezistentných patogénov.
- Potvrdzuje, že Bacillus spóry sa môžu aktivovať na povrchoch a pomôcť "nahradiť" patogény bez povzbudzovania AMR.
4) Probiotic cleaning products: A sustainable and safer approach to environmental cleanliness
Probiotické čistiace prostriedky: udržateľný a bezpečnejší prístup k environmentálnej hygiene
- Systematicky zhodnocuje štúdie o probiotických čistiacich prostriedkoch, ich mechanizme (konkurenčná exklúzia, biofilm modulácia, antimicrobálne peptidy) a ich potenciál pri znižovaní environmentálneho rizika v hygienických aplikáciách.
Relevantné aspekty:
Probiotiká môžu
potláčať patogénya podporovať prospešné mikroorganizmy bez nevýhod chemických látok.
Uvádza mechanizmy ako
produkcia bacteriocínova narušenie patogénnych biofilmov.
5) Can probiotic cleaning solutions replace chemical disinfectants in dental clinics?
Môžu probiotické čistiace roztoky nahradiť chemické dezinfekčné prostriedky v zubných ambulanciách?
- Skúmala účinnosť probiotického čističa (Bacillus subtilis) v prostredí zubnej kliniky.
Zistenia:
- Probiotické čistenie výrazne znížilo počet bakteriálnych kolónií na povrchoch v porovnaní s chemickými dezinfekčnými prostriedkami.
- Krátkodobé údaje o znížení rezistencie neboli výrazné, ale výsledky poukazujú na zlepšenie hygieny.

Mikroorganizmy v PETRIHO MYSKÁCH
